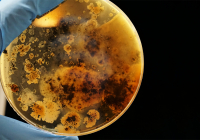

Media
26. Aug. 2021
Team of Czech scientists discovered how to make CAR-T cell therapy in haematological malignancies more effective
Press release; Veronika Mancikova, Michal Smida and their colleagues from the Functional Genomics Research group based at CEITEC MU, in…
24. Aug. 2021
World Media about Professor Rektor's research on the ‘Mozart Effect’
‘Mozart effect’: Listening to composer’s Sonata For Two Pianos K448 can prevent epileptic seizures, study finds A piece of music by Mozart can have…
5. Aug. 2021
Proč selhává léčba rakoviny? Na vině může být i protein chránící rakovinné buňky
Proč je u některých lidí léčba rakoviny úspěšná, a u jiných ne? Dosud neprobádanou příčinou nezdaru by mohl být klíčový protein metalothionein, který…
3. Aug. 2021
New versatile genetic test for lymphoid neoplasms supports personalized management of patients and further research
Researchers reporting in The Journal of Molecular Diagnostics have developed the LYmphoid NeXt-Generation Sequencing (LYNX) panel that analyzes both…
24. May 2021
Martin Pumera: Nanorobot může čistit životní prostředí nebo extrahovat uran
O tom, co je vlastně nanorobot, jak ho můžeme využít a proč, promluvil univerzitní profesor a vedoucí výzkumu nanorobotů Martin Pumera. Zdroj:…
11. May 2021
Using microrobots to eradicate bacteria
Article by by Lucie Bradley (May 7, 2021) A team of scientists have created a cost-effective way to destroy bacterial biofilms, paving the…
6. May 2021
Storage for Science Data by the Most Powerful Supercomputers in Europe Will Be Developed in Ostrava and Brno
The new technology platform is now being developed in Ostrava and Brno, to help with scientific data processing using the most powerful…
27. Apr. 2021
Překódovat si mozek
Díky schopnosti našeho mozku "předrátovat se" můžeme změnit zaběhnuté vzorce myšlení a chování. Opustit ty, které nám škodí, a přeladit se na nové,…
27. Apr. 2021
CEITEC je Slavia české vědy, říká Tomančák. Šéfovat mu bude z Drážďan
Ve světě je brněnský Středoevropský technologický institut, známý jako CEITEC, podle jeho nového šéfa synonymem pro úspěch české vědy. I to rozhodlo,…
26. Apr. 2021
Brno scientists developing nanorobots for surgery, attacking cancer cells
Scientists in Brno are developing miniature robots – no bigger than a virus and so invisible to the naked eye – capable of performing surgery. Due to…
Shown 10 of total 180 records.